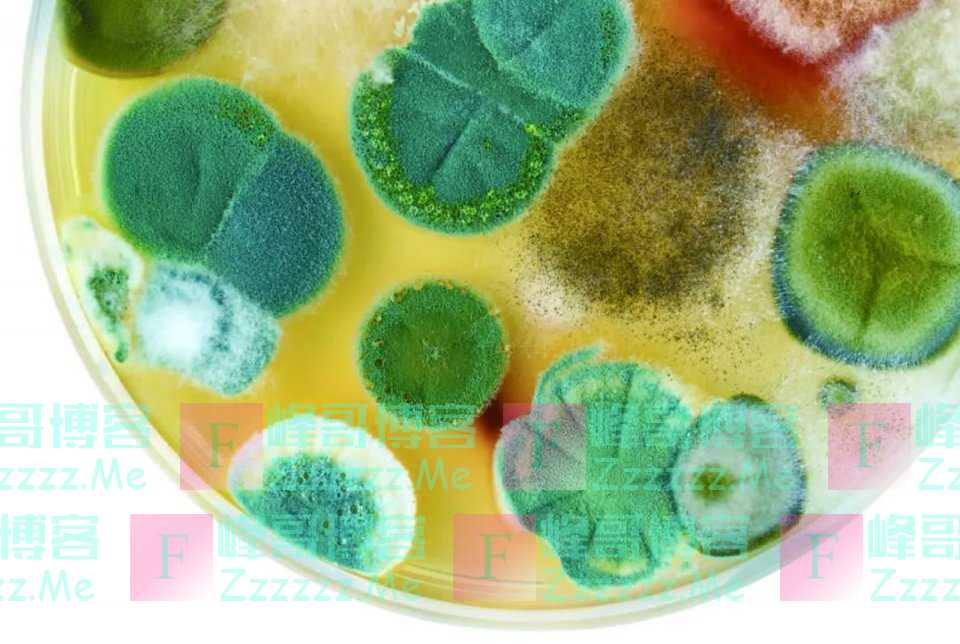

盘尼西林(Penicillin)即我们俗称的“青霉素”。在今天,青霉素是一种很常见的抗菌药品,在药店里随处可见。可在60年前,盘尼西林是比黄金还贵重的药品。

俗话说:“失败是成功之母。”这是宽慰失败者的心灵鸡汤。可盘尼西林真的是一次实验失败的产物。
盘尼西林的发明者叫亚历山大·弗莱明(Alexander Fleming)。弗莱明是英国人,出生于1881年8月6日——那一年,中国文豪鲁迅出生于9月25日。
弗莱明家庭条件不好,因此13岁就跟着哥哥到伦敦去打工谋生。没过多久,他的姑父去世,这让他得到了一笔意料之外的遗产。弗莱明将这笔遗产作为学费,到伦敦大学圣玛丽医学院(St Mary's Hospital)学习医学。1906年,弗莱明毕业后,留在学圣玛丽医学院进行医学研究。1908年,弗莱明获得了医学博士学位。

圣玛丽医学院现在属于伦敦帝国学院,威廉王子、哈利王子、夏洛特公主、狄奥多拉公主等英国皇室成员都在这里出生,因而闻名遐迩。
1914年,第一次世界大战爆发后,弗莱明中断了医学研究,到法国战地医院工作。
在第一次世界大战中,受恶劣的战争环境影响,无数士兵在受伤后伤口感染了病菌。如果是现在,伤口感染纯属“小儿科”。可在20世纪初,当时的医学技术,对病菌感染毫无办法。弗莱明只能眼睁睁地看着士兵被病菌折磨而死……当弗莱明儿时的伙伴迈克也因伤口感染而死去时,不禁落泪了。

弗莱明在医院的圣母像前发誓:“万能而仁慈的圣母,我愿以我的生命和灵魂向你起誓,穷我一生之力,也要消灭病菌,无论付出什么样的代价,也无论前路如何渺茫。只要我还活着,终将至死不渝。”
战后,弗莱明投入到克制病菌感染的研究中,几年如一日忘我的研究,可是,这些研究都无一例外的失败了。
1928年夏天,弗莱明在培养葡萄球菌时,其中的一个培养皿因失误,长出了一团团青绿色的霉花,而在霉花的周围,那些葡萄球菌不见了。在20世纪初,这样的试验错误比比皆是,实验者会将失误的培养皿扔掉了事。可弗莱明没有扔掉培养皿,而是敏锐地想到:会不会是这种霉花将葡萄球菌杀死了呢?
事实证明,弗莱明的想法是正确的。这种霉花对葡萄球菌等细菌有很大的毒性,对白细胞却没有伤害。不过,由于弗莱明不是化学家,没有能力将这种霉花提纯。他只有将自己的发现写成论文《关于霉菌培养的杀菌作用》,发表在《不列颠实验病理学杂志》上,等待后来人来解决提纯的问题。
10年后的1939年,英国病理学家弗洛里和生物化学家钱恩根据弗莱明的文章,重复了他的试验,提纯了这种被称为盘尼西林的药物,并用于临床应用上。
为此,弗莱明、弗洛里和钱恩以“发现青霉素及其临床效用”共同获得了1945年诺贝尔生理学奖(医学奖)。

第二次世界大战爆发后,盘尼西林成为战场上的治病良药,挽救了无数受伤士兵的生命。盘尼西林因此成为第二次世界大战中与原子弹、雷达并列的三大发明之一。不过,在二战爆发之初,由于生产条件的限制,盘尼西林的产量很低,使得它的价格非常昂贵。
如果那时候你拥有100斤盘尼西林,将会轻而易举地成为千万富翁。
100斤盘尼西林,等于50千克,即5000万毫克。1毫克为1670单位。在1943年时,一支40万单位的盘尼西林售价约200美元。经过简单计算可以得出,100斤盘尼西林价格约为4200万美元。

二战时期,美国下饺子一样制造了100多艘航空母舰,平均每艘航空母舰的造价大约为800万美元。这就是说,100斤盘尼西林,能换来5艘航空母舰。厉害不?
当然,如果你真的有100斤盘尼西林,那么我建议你在1943年底之前就要全部卖出去,否则的话,等到1944年美国实现了大规模量产后,这100斤盘尼西林就不值钱了。
1944年,一支40万单位的盘尼西林售价约1美元,等于降了200倍。4200万美元立即缩水到21万美元。惊不惊喜?意不意外?
【参考资料:《盘尼西林――拯救数十亿人类的奇迹》等】
文章如无特别注明均为原创!
作者:
F_Robot,
转载或复制请以
超链接形式 并注明出处 峰哥博客。
原文地址《
二战时拥有一百斤盘尼西林,能带来多大的收益?》发布于2020-4-12
若您发现软件中包含弹窗广告等还请第一时间留言反馈!
小米手机无法安装请到设置->开发者设置->关闭系统优化,安装后再开启系统优化。
